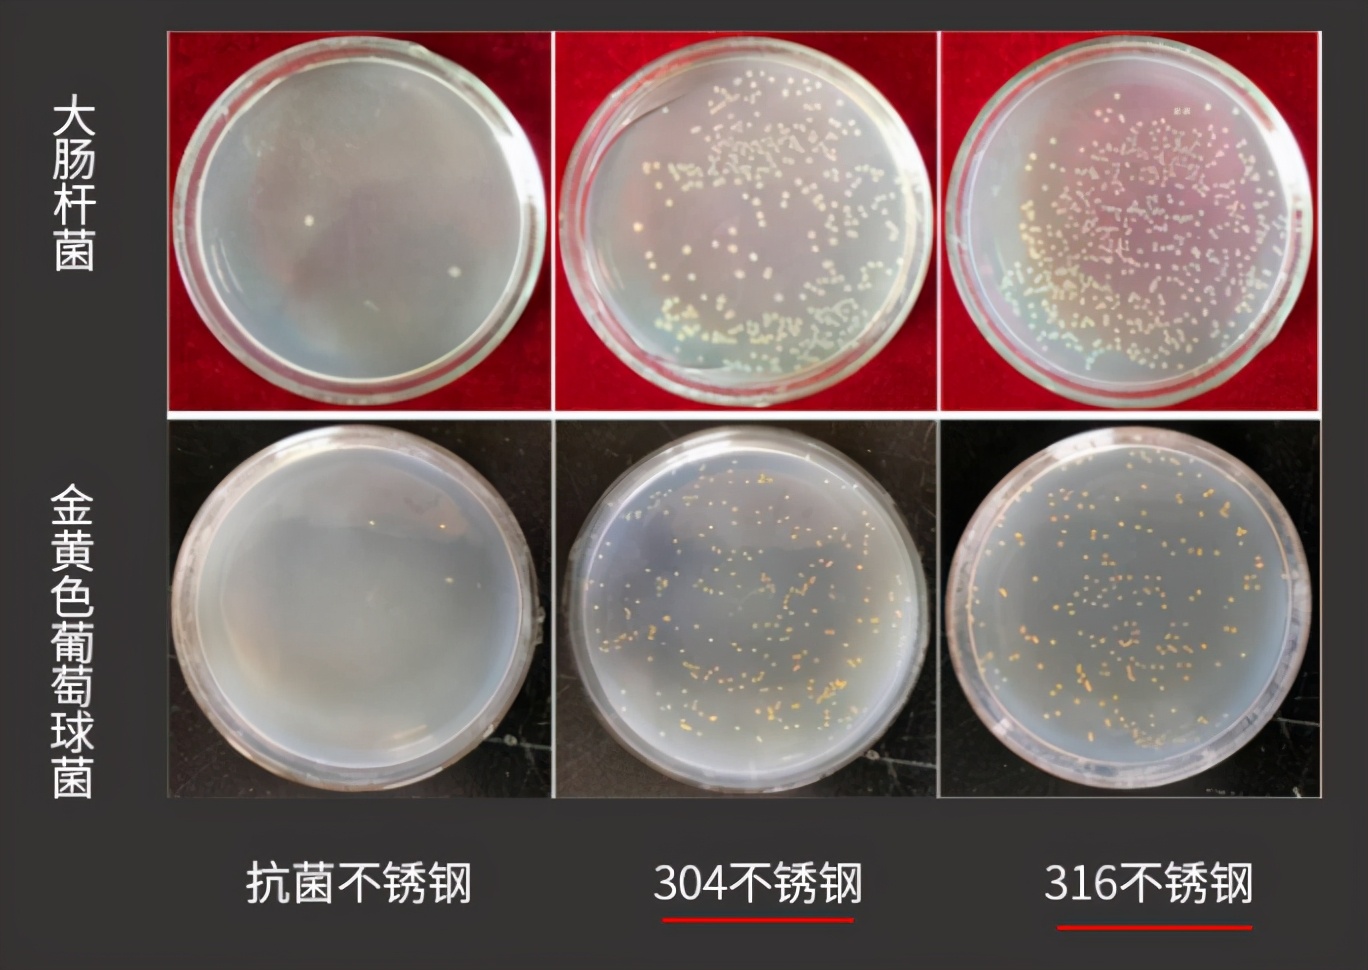
中科院抗菌不锈钢筷子是真的吗,中科院抗菌不锈钢符合食品级吗

用来每天吃饭的碗,你知道有多少种类吗?
根据碗的不同材料来分,可以分为:陶瓷碗、搪瓷碗、塑料碗、玻璃碗、不锈钢碗等。
你有用过哪几种的碗呢?

现在很多的家庭主要是用的陶瓷碗,样式多、造型好看,也容易清洗,一般都选择无彩釉的(彩釉含有铅等重金属,而且容易脱色),但是有个比较明显得缺点,很容易碎,只要掉地上了就基本上会摔坏。
小的时候家里用过搪瓷碗,摔不坏,但容易掉漆生锈,析出重金属离子,出现这种情况就坚决不用了,现在很难见到有这样的碗了。

塑料碗用得很少,还是之前上大学的时候,在学校的食堂有用过这样的碗,家里从来没用过,这种碗容易变色、且起划痕,最好只盛米饭,不能盛装高温的食物。因为塑料有很多种类,在选购的时候,一定要挑PP材质的,符合国家标准的食用级塑料。

而从使用安全的角度来说,玻璃碗可能是最好的选择,不含有机的化学物质,不会渗出有害物质。但是生活中几乎很少看到有人用玻璃碗来吃饭,易碎、烫手、冷热交替使用容易炸裂等缺点,直接就限制了使用。

最后想说的是不锈钢碗,重量轻、坚固耐用摔不坏、容易清洗,这种碗已经出现在了很多家庭的橱柜中了。市面上它的材质主要是304不锈钢,也有316不锈钢的,但价格会贵很多,这两种不锈钢材质都是食品级别的,符合国家食品安全标准。
当然,在吃的问题上,都是希望能够更加健康。中科院金属研究所为解决健康吃饭的民生问题,用了5年时间来研发抗菌不锈钢,突破了传统碗的缺点,抗菌效果超过了99%,并且也通过了食品安全标准的测试,填补了国内相关材料的空白。

跟现有的304和316不锈钢相比,抗菌效果非常显著,同时它的抗菌性具有持久性和广谱性,不会随着使用的时间变长而抗菌效果减弱。
有着304一样的物理性能,但却有着99%的抗菌效果,这一突破材料获得了国家发明专利,足以看出这项发明的重要性。

这些年,抗菌不锈钢的应用开始广泛起来了,在餐具上的应有,给到了人们另一种健康的选择。
吉高(Geego)在健康餐具的不断追求,很早就开始用抗菌不锈钢来做不锈钢碗了,凭借在不锈钢餐具领域多年的经验和技术,推出的不锈钢碗获得了很多用户的喜欢。

99%的抗菌效果,可以24小时保持食物的新鲜,通过跟304不锈钢碗对比,把食物装在碗里24小时,食物要比304不锈钢碗里的新鲜很多。


除了具有很好的抗菌保鲜效果,在工艺设计和制作上,Geego不锈钢碗也是不同于一般的碗。
采用了双层中空隔热保温设计,内外层均采用抗菌不锈钢,往碗里倒刚煮开的水,捧在手里也不会觉得烫手,测试温度大约在40℃左右,平时往碗里盛饭盛汤,都能马上端起来。

中空的设计不仅有隔热的作用,还有很好的保温效果。家里面有宝宝的都知道,为小孩子吃饭或者他们自己吃饭,时间都比较久,碗里的饭很容易就凉了,Geego不锈钢碗能最大程度地给饭保温,吃饭更放心。

在用料方面,并没有因为采用抗菌不锈钢而减少用料,反而采用了加厚设计,非常地抗摔耐用,家里的小孩子怎么摔都不会破损。

工艺上,使用了拉丝+镜面抛光工艺,使得碗看上去、用上去更具有生活品质。
碗的外部上半部分,采用了拉丝工艺,非常地具有质感,有且仅有一个“福”字,没有多余的修饰。

碗的内层则采用了镜面抛光,看上去非常的干净,清洗也方便,没有洗干净一眼就能看到,减少细菌的藏身之处。

Geego不锈钢碗有两个尺寸,有个儿童款的,可以装378ml;还有个成人款的,可以装500ml,满足一家人的需要。

越来越多人选择不锈钢碗,中科院研发的抗菌不锈钢,99%以上的抗菌效果,让一家人吃饭更加放心和健康。
点击下方链接即可购买!
Geego抗菌不锈钢碗
¥39
购买